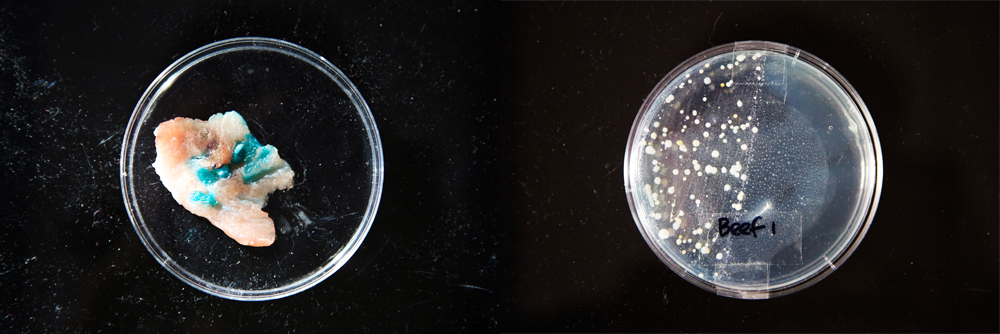

Documentation
Ch4. Methodology
The research direction of this thesis emerged from an interest in developing autonomous interactive systems. The following chapter details my explorations from fall 2012 till present. My process can be divided into two stages: 1) Interfaces for Insects and 2) Interfaces for Bacteria.
4.1 Interfaces for Insects, Fall 2012
The idea that technological process are essentially organic has such a long history that it is impossible to locate its origin. It has been argued that the first tools were themselves organic: animal bones, teeth and antlers.[81]
[81] Channell, David F., The Vital Machine: A Study of Technology and Organic Life. New York, Oxford: Oxford University Press, 1991.
Early technologies were closely associated with nature and life. Ancient furnaces were designed in the shape of an egg. Many myths concerning the origins of metal believed that minerals contained a living force and developed in the earth much as a fetus would develop in the womb. Throughout history, disconnect between our concept of natural phenomenon and technological processes gradually developed and in today’s mainstream, technology is portrayed as invasive and imposed. I am interested in looking back into these prehistoric concepts of the machine and reexpressing them through my work in contemporary context.
What I sought out to create was a series of living machines that not only ran on artificial fuels such as electricity, but also depended on biological systems for functionality. Similar to morphology within natural species, the form of this technobio hybrid would be determined by its purpose, namely, interfacing technological and biological realities to create phenomenological effects. Therefore, depending on the behavioral characteristics of the species integrated into the machine, the interface would differ and thus change the form of the hybrid. Even when the technological component had the same functionality, for instance electric stimulation, with different organisms, the end-form of the machine would still be different. Furthermore, the machine would acquire life-like features such as obtain life cycles, life spans, etc.
An intentional decision was to deny human interference in the technological process of the hybrid machines, and create interfaces that are only accessible to the other organisms embedded within the system. Influenced by Jussi Parikka’s Insect Media: An Archaeology of Animals and Technology, I was fascinated with the perspective of insects and the alien life they presented. Looking to insects for technological inspiration is nothing new. Many state-of-the-art robotic platforms (especially ones used for outer-space exploration) have been inspired by the behaviorisms of these miniature creatures. The hexapod robot Sprawlita imitates the leg locomotion of insects in exploring possibilities of a robotic system that can travel sufficiently over diverse terrains[82]. In the wheeled mobile robot Sahabot 2, researchers were successful in employing algorithms based on the behavior of the ant Cataglyphis for path integration and visual piloting[83]. The Cockroach Controlled Mobile Robot developed by Garnet Hertz strived to create a pseudo-intelligent system with a Madagascan cockroach as the CPU[84]. Such past explorations can be categorized into two groups: 1) technological imitations of insect mechanisms that resides in the realm of biomimicry and 2) control systems that cater to insects within interface design. I was fascinated with the latter. But unlike Hertz, my interest lay in emergent behaviors within insect swarms that contributed an element of uncontrollability and unpredictability to the designing of control systems.
[82] Benvenuto, Antonella, Giovanni Di Pino, Fabrizio Sergi, Demenico Campolo, Dino Accoto, Giovanni Assenza, Paolo Maria Rossini and Eugenio Guglielmelli. "Machine/Animal Hybrid Controllers for Space Applications Final Report".
[83] Benvenuto, Antonella, Giovanni Di Pino, Fabrizio Sergi, Demenico Campolo, Dino Accoto, Giovanni Assenza, Paolo Maria Rossini and Eugenio Guglielmelli. "Machine/Animal Hybrid Controllers for Space Applications Final Report".
Projects that involve biological organisms or even organic matter often take several years to accomplish (Ant Ballet[85] and Silent Barrage[86] both took 7 years). Besides developing the technology needed, much time is committed to the study of the species involved. Due to the constraints of thesis, I decided to focus on a single prototyped iteration of my concept that combines an ant colony with a magnetic core memory chip. Ants are social insects with complex communication systems, and more significantly, they have an affinity to electricity. It is a well-documented fact that ants often cause damage to electric equipment because they are attracted to the voltage fields and often end up shorting the circuit[87]. The reason for this attraction is still largely a mystery. What’s intriguing is these insects were able to adapt and develop a symbiotic relationship with electric devices in only the century that artificial electricity has existed. This relationship fits well into my concept of the animalmachine.
[86] silentbarrage.com
My interest in the magnetic core memory chip began while I was working on The Silkworm Project in spring of 2012. The magnetic core was the predominant technology used for computer memory storage between 1955 and 1975[88]. It utilized magnetic fields created by electric current to control the polarity of circular magnets within a matrix. By flipping the direction of the current, the system is able to change the magnetic direction of each magnet, and in doing so, writing and re-writing the memory between two options that represented 0 and 1. This physical form of what we know as the digital bit resonates with Delanda’s view of information storage and material memory that bridges the gap between the artificial and the organic, the nonliving and the living. What’s more, Ben North and Oliver Nash reinvented a contemporary 32-bit version of the magnetic core that can be easily printed (via PCB printers) and assembled, and is compatible with the Arduino. This technology has been released into the open source domain and is accessible to all.[89]
In summary of the above, a theoretical process of information transfer can be created to bind the technical and the organic, in this case, computational memory and the ant colony. The collective living memory of the ants can potentially be recorded within the computer’s memory and become machine memory. However, for this to happen, an interface must be created that both caters to the activity of ant swarms and provide incentive to motivate them to interact with it. Ants are natural scavengers and builders, and they will scavenge and build even without the presence of a queen and social order. A possible solution is to use materials that ants utilize in their construction to build an electronic interface (there are ant gels that can easily be purchased with ant farm online, these gels provide both food and construction material for the ants). As the ants deconstruct and re-appropriate the materials, they break electric connections or recreate new connection, sending a signal to the machine that can be recorded as memory. The transfer of information therefore becomes twoway in that organisms provide living memory to the machine and the machine provides material information for construction of social bonds within the organic swarm. The interface itself becomes ephemeral and the hybrid machine selfterminates when deconstruction reaches a point of dis-function. (See Fig. 2)
 Fig.2 Information Transfer Diagram between the Artificial and the Organic
Fig.2 Information Transfer Diagram between the Artificial and the Organic
Regrettably, this first stage of development remained largely conceptual. A main reason is due to the complexity of the organism I chose to work with and failure in connecting with an entomologist. Furthermore, it is easier to acquire ants in the spring, especially queen ants that can’t be bought. Without a queen, ants do not necessarily express social behavior and the colony will die within a few days at the end of the individual ant’s life span. These challenges drove me to search for a 37 different organism that was easier to work with: a lower level organism that provides a faster turnover rate for observing experiment results, is non-seasonal and easy to acquire.
4.2 Interfaces for Bacteria, Winter 2012 - Spring 2013
My first experience with bacterial artwork was at the Geek Down – New Biologies show at 92YTribeca in September of 2012 where I first met Nurit Bar-Shai who is one of the founders of Genspace, a community bio lab in Brooklyn, NY. Her piece Objectivity [tentative]: Sound to Shape[90], a collaboration with Nils Kesler, creates beautiful shapes of bacterial growth with the Paenibacillus vortex bacterium (a type of sensitive bacteria that forms communication networks within the colony) by stimulating them with sounds of different frequencies. I was very much intrigued by the fractal growth patterns of these microorganisms in response to stimulus. Bacteria presented a life form that was even further beyond human experience and comprehension and more mysterious.
[90] Sound to Shape, Geekdown: New Biologies, Nurit-Bar-Shai and Nils Kesler
Towards the end of November 2012, I began a series of electric stimulation tests with meat to see how that would affect bacterial growth (see Fig.3). Francis Bacon was the first to discover that high voltage electric shock enhances muscle tenderness and creates a better taste in meat. High voltage stimulation is also a common method used in the meat industry to sterilize food products and delay the growth of bacteria. However, within medical studies, research show that a higher level of bacterial growth exists on static electric surfaces such as monitors in surgical rooms, which can cause possible contamination. It appears that the relationship between bacteria and static electricity fluctuates between the ends of life and death, and I was interested in exploring the nuances in between.
Fig.3 Information Transfer Diagram between the Artificial and the Organic
Fig.3 Information Transfer Diagram between the Artificial and the Organic
In my experiments, I wanted to see whether electric stimulation would aid in the growth of colonies within the meat or possibly attract airborne bacteria. Using a DIY kit purchased from Amazon, I cultured plates of bacteria from 3 different scenarios: 1) wrapped meat with no stimulation; 2) wrapped meat with 30v stimulation for 5 min; 3) exposed meat with 30v stimulation for 5 min. I repeated these tests across lamb, pork and beef, taking samples from the same slab within each type. The test results were confusing and uninformative, and after talking with two bacteria artists from the UK, Anna Dumitriu[91] and Simon Park[92], I realized that not only were my experiments potentially hazardous, but also, they were done in a very uncontrolled environment using unprofessional methods, which made it hard to draw any conclusions. I needed to find a biology lab with professionals where I could safely conduct experiments and learn the appropriate protocols to prevent contamination.
Genspace, a community bio lab in Brooklyn[93], provided such an environment for me. I had heard about the space in September 2012 from conversations with Nurit who was one of the founders. The lab is the first community bio lab to open in the United States. It allows open access to simple biology classes and hands-on experience in a molecular lab in promotion of the idea of citizen science. The space offers workshops that present a wide range of interests, from synthetic biology and microorganisms such as slime mold to brain cell staining methodologies and DIY gaming systems that utilize living organisms. I began taking courses at Genspace in late January and by mid February became an official member.
[93] genspace.org
Genspace is a biosafety level 1 lab[94], which means it provides a suitable situation for working with well-categorized agents that are not known to consistently cause disease in healthy adult human beings and have minimal potential hazard effects on lab personnel and environment. Because the bacteria I sampled from the meat was unknown, therefore uncategorized, and because meat is a nutrient environment much similar to the human body, which meant the bacteria that resides in it are more likely to be pathogens, my previous experiments exceeded the affordances and regulations of the community lab. I had to change my design and experiment methods. Since the main goal of my exploration was not fixated on meat specific bacteria species, but rather more to observe a general bacterial response to artificial electric environments, I decided to focus on creating a dynamic platform for interfacing electricity directly with bacteria cultures.
[94] Biosafety level
 Fig.4 Early mock up of how electronics can be embedded into petri dish.
Fig.4 Early mock up of how electronics can be embedded into petri dish.
I devised an electrode array system that provides voltage stimulation where each individual electrode’s voltage value could be adjusted separately to create nonunified, diverse and possibly dynamic voltage field environments for experimentation. As shown in the diagram, the electrodes are directly embedded into the plate and separate from the control circuit. The circuit can be easily plugged into the electrodes and sit on top of the petri plate. This mechanism allows sufficient insulation of the electronics as well as direct contact between electrode and organic matter within the plate (see Fig.4). Furthermore, one can easily unplug the controller for reuse without dismantling the bacteria culture. With the help of Dr. Oliver Medvedik[95], I also developed a series of three protocols that were specific to my project: 1) Creating and prepping electronic plates, 2) Voltage testing of electronic plates, 3) Setting up stimulation experiments for bacteria. These operations experimented with merging common procedures in both the molecular lab and the electronics lab.
[95] Co-founder of Genspace, molecular biology PhD and professor at Cooper Union.
In the process of creating and prepping electronic plates, I mainly experimented with two different methods. But before we jump into the specifics of each, it is necessary to introduce the common way of prepping plates for bacteria experimentation. In history, there are three main ways of culturing bacteria: 1) Liquid media, 2) Solid media and 3) Ecological systems. Louis Pasteur first started culturing bacteria in broths of urine and meat extract. Today, this method has been updated to us liquid mediums such as LB liquid, which I will talk about again in the following. Robert Koch developed the method of culturing bacteria on solid surfaces, such as potato pieces. Under the suggestion of Fannie Eilshemius, wife of Walther Hesse (assistant to Koch), Koch eventually adopted agar as a solid media for surface culturing. This method allows for more control of the amount of bacteria seeded and remains a dominant method in labs today. Lastly, Sergei Winogradsky devised the Winogradsky column that allows for a variety of bacteria to grow within a single ecosystem. This method remains an important display of chemoautotrophy and microbial ecology to this day. I mainly use agar surfaces to culture my bacteria experiments, specifically, LB (Luria Bertani) media. The agar is prepared by autoclaving an LB powder and water mixture, which sterilizes and evenly melts the nutrient mix. Once autoclaved, the liquid media can be poured into petri plates to set and solidify for later use. Unlike most petri plates, my electric plates needed to have holes drilled into the bottom for embedding electrodes. This posed two problems: 1) the agar in it’s liquid form needs to be contained before it solidified, 2) the holes needed to be sterilized and protected from contamination until the time plates are needed for experimentation.
 Fig.5 Soldering station setup under sterile vacuum hood at Genspace.
Fig.5 Soldering station setup under sterile vacuum hood at Genspace.
I set up a sterile soldering station within a vacuum hood and used the heated soldering tip to burn holes into petri dishes. I used a protoboard as a template for accurate spacing between the holes so that header pins would easily fit into the plates. The heated solder tip provides that the holes are sterilized. From there, I conducted two sets of processes as a comparison. The first, which we shall call method 1 for clarification, embedded sterilized header pins into the plates to seal the holes for pouring agar. The second, method 2, sealed the holes with sterile aluminum tape and removed the tape to embed header pints only before the plates are needed for testing. Method 2 proved more sufficient. For one, it made sure there was no agar leakage while the LB liquid media solidified in the plates. It was easier to store because you didn’t have to worry about header pins falling out and contaminating the plates and without the pins, a stack of plates took less space in the fridge.
 Fig.6 Petri dish prep experiments at Genspace.
Fig.6 Petri dish prep experiments at Genspace.
Once the electric plates with agar are made, voltage testing was necessary. Because LB media is an organic material, and because it is largely water-based, it becomes a sufficient electricity conductor between electrodes and bacteria. However, it is important to understand how much voltage is being expressed on the surface of the agar, in other words, how much voltage the bacteria is actually being exposed to. Here, I would like to first briefly talk about the development of my control circuits, which can be divided into three stages. These stages present different voltage testing results that informed my understanding of how electricity passed through the agar plate.
 Fig.7 TPS71501-Q1 Chip (Left), Control Circuit Protoboard Version (Right)
Fig.7 TPS71501-Q1 Chip (Left), Control Circuit Protoboard Version (Right)
The main component of my circuit is the 50-mA, 24-V Supply Current Low- Dropout Linear Regulator (part# TPS71501-Q1, SC70 Package). The chip offers the benefit of high input voltage and low-power operation. The application circuit also allows adjustment of the output voltage from the chip. Each electrode value could thus be controlled by one chip. Electrodes could be connected in parallel to each other, so each node would have the same maximum input voltage value that could be dropped and adjusted within an output range. In the first stage of my electronics development, I created a board that only connects the electrode to the agar without grounding the plate. When testing the voltage of the agar, the materials expressed 71% - 78% of the total voltage measures directly on the electrode. The voltage values fluctuated constantly on all part of the stimulated agar, but the percentage range for fluctuation remained relatively stable. Furthermore, the reduction of voltage didn’t seem to have any direct relation with the distance between the multi-meter’s probe and the electrode, the agar was much like a capacitor where voltage was evenly spread. Also, I noticed the agar in the plate melting slightly in the areas connected to the multi-meter probe, which could possibly be where current is formed and the slight heat from the current is melting the agar. A few sustained stimulation tests with bacteria confirmed that without grounding the plate, there was no voltage being expressed on the agar gel. And so, I developed two more circuit boards, one that provided single voltage value stimulation that also grounded the plates, another with two different voltage value stimulations that are separately connected to a common ground that is also connected to the plate. Voltage tests with these circuits have shown a lower percentage of voltage expressivity. Also, after sustained electric stimulation, some plates show rippled effects on the surface of the agar gel. After talking to Nurit, she told me that when she stimulated her bacteria with sound, similar ripples would appear on the surface of the agar as well. I am still uncertain exactly what is happening to the materials, but this phenomenon of molding matter through invisible forces is definitely worth further exploration.
 Fig.8 Single Voltage Ungrounded Circuit (Left), Single/Dual Voltage Grounded Circuit (Right)
Fig.8 Single Voltage Ungrounded Circuit (Left), Single/Dual Voltage Grounded Circuit (Right)
 Fig.9 Single Voltage Ungrounded Voltage Measuring Setup (Minus multimeter and power source)
Fig.9 Single Voltage Ungrounded Voltage Measuring Setup (Minus multimeter and power source)
With intuitive experience of electricity’s behaviors in agar, we are then ready to set up stimulation experiments with actual bacteria. For this specific case study, I used the JM109 strain of E. coli. There is no particular reason for my choice, except that such lab-modified strains of E. coli are among the most commonly used species of bacteria in bio labs for experimentation. I felt it was a good choice to develop my research methodology and gain basic understanding of preliminary bacterial responses. E. coli grows very fast, within a 37 C incubated environment, visible colonies only take a day to emerge, which makes the turnout rate of tests fast. A day before planned tests, a plate of stock bacteria should be streaked and left overnight to grow. This insures that the bacteria you use for the tests are fresh. Broth cultures are used to provide bacteria mixtures for the preparation stage before seeding. In my experiments, I use LB broth. Unlike LB media, LB broth does not solidify after autoclaving, but remains a liquid form. With sterile wooden sticks, scrape a small portion of E. coli from the stock plate and dip it into a tube with LB liquid while stirring, then use a centrifuge to ensure an even mix of the bacteria in the liquid. A sample of this mix should be taken and used with the spectrophotometer for cell counting. When measuring growth, it is always good to know the density of the cells before plating, especially with methods of seeding such as even spread. Because the amount of bacteria scrapped from the stock plate can be random, sometimes the density of the cells in the mix might be too much for test purposes. In this situation, serial delusions can be conducted on the bacteria mixture.
 Fig.10 Two examples of electrode configuration design (blueprint)
Fig.10 Two examples of electrode configuration design (blueprint)
There are different ways of plating bacteria, the two main methods that I have used in my tests are even spreading over the plate and seeding one or multiple drops of bacteria at specific positions on the plate. I designed a series of possible electrode configurations blueprints within the framework of the petri plate and ask questions and for each design, there are multiple possibilities for seeding that are also designed in relation to the spatial relations of the electrodes. Both electrode and seeding designs pose different questions of how the bacteria might react to electric stimulation. Because chemical reactions between the metallic electrodes and the agar media happen during electrocution, therefore, electrodes made of different materials can cause different effects on the bacteria culture. In the beginning, I used gold plated electrodes. Most header pins are made of copper, when electricity passes through the copper electrode, the metals react with the agar and oxidizes and becomes toxic. This may kill the bacteria culturing plated in the petri dish and affect the result of the test. Gold is the most stable element in the periodic table is which makes the rate of chemical reaction with other elements extremely slow. However, after a few weeks of sustained electric stimulation experiments (some as long as 30 continuous hours per session), the gold plating burned out and I was left to work with copper header pins.
Contrast to my original belief, bacteria still grew in plates that used the copper pins for stimulation. In fact, these test results proved far more interesting than the previous ones using the plated gold pins. Oxidized copper turns a turquoise green (GND pin), the coloration helped visualize the electric field and it’s effect on the agar. In single voltage stimulation tests where the plate also had a connection to ground, the agar would split in the middle between the electrodes. Agar cracks under dry conditions, which meant the mid area between the electrodes dried up faster than other areas on the plate. This could be due to a higher level of current running through, causing dehydration of the agar. What was especially interesting was the visualization of voltage fields of dual voltage level stimulation. The lower voltage point became the sink in place of ground.
 Fig.11 Test Results, single and dual voltage stimulation with GND connection
Fig.11 Test Results, single and dual voltage stimulation with GND connection
The bacteria tended to grow more on the upper and lower edges of the plates, positions that were furthest from the electrodes. In some plates, bacteria managed to grow also on the area of split agar in between electrodes, sometimes merging with the oxidized copper. Fig. 12 shows one of my most interesting test results. I seeded 5microL of bacteria in the center of the plate between the electrodes. After 30hrs of stimulation, the voltage fields (1V) were somehow able to push the bacteria symmetrically to the sides of the plate. The two darker dots near the top and bottom boarders of the plate are bacteria colonies that were able to develop. Of course, there is still not enough experimentation to draw conclusions. Scientific study often needs abundant data that remains consistent throughout before meaning can be made. More experimentation is obviously needed here.
 Fig.12 Test Result, bacteria seeded in center of plate was pushed to edge of plate to
form 2 colonies.
Fig.12 Test Result, bacteria seeded in center of plate was pushed to edge of plate to
form 2 colonies.
Lastly, I would like to briefly touch on the matter of bacteria preservation for the purpose of exhibition. Bacterial work are usually killed before displayed in art spaces, and also preservation is necessary to avoid deterioration of organic materials as well as new bacteria colonies forming on the agar. I experimented with both alcohol and bleach in killing the E. coli. Alcohol will not sufficiently kill E. coli, and also, it vaporizes very quickly, after which new bacteria may still grow on the plates. Bleach is often used in labs to kill E. coli before disposing them in the trash, but the bleached plates turn a yellowish color which can be undesirable (compare fig. 11 and 12). Last, the agar dries after a few days of display (especially under or above strong lighting) and begins to form cracks that are not part of the original test results, which can be problematic. Further research of alternative preservation method is necessary.
Ch5. Plans for Future Research
This project is an exploration in the merging of scientific and artistic methodologies in creating contemporary art. It advocates the concept of research as art practice, where the production timeframe is largely dictated by the requirements of research and experimentation. The work accomplished in the past year only serves as a starting point for further exploration. The following presents plans for future development of this piece.
5.1 E.coli
I would like to conduct further tests with E. coli, to refine my current methodology, set up a more systemic structure for questioning and analyzing emergent bacterial phenomenon in results, and exhaust possible questions asked that are specific to E. coli, solid surface culturing and electric voltage stimulation. Such questions include: What is the life and death boarder-line voltage value for E. coli? How does density influence the survival rate of bacteria under electric shock? Specifically, how does the electricity affect bacteria life processes on a micro level? Is it possible to visualize the electric fields via bacteria growth on the plate?
I would also like to experiment with other ways of culturing E. coli, for instance broth culturing, or semi-solid culturing, etc.
5.2 Other Bacteria Species
Once I have developed a solid methodology and thorough understanding of the current case study, I hope to venture into other bacteria species, species that may be more sensitive to electro-magnetic fields, produce electricity themselves, and even use electricity to communicate throughout the colony. Most of these types of bacteria reside in pond mud or in the deep sea, water provides an ideal conductive environment for electricity. However, some of these species are hard to acquire and I would need to work with a professional biology lab that has access to such strains to be able to conduct some of these researches.
In addition, I am also interested in the chemical bacteria ecosystem structure of the Winogradsky columns and would like to develop a specific electronic interface for stimulating layered bacteria ecologies.
Other Organisms
Last, the electric plates developed in this thesis are not only specific to bacteria, but can act as stimulation interfacing for any organism that can be cultured in the petri plate. Therefore, I hope to expand research into other organisms as well with this project. A current interest focuses on slime mold networks. Slime mold differs from bacteria in the fact that they are more mobile and can move around in the space of the petri dish. It would be very interesting to document their movement through timelapse video.
Bibliography
Channell, David F., The Vital Machine: A Study of Technology and Organic Life. New York, Oxford: Oxford University Press, 1991.
Parikka, Jussi, Insect Media: An Archaeology of Animals and Technology. Minneapolis, London: University of Minnesota Press, 2010.
Benvenuto, Antonella, Giovanni Di Pino, Fabrizio Sergi, Demenico Campolo, Dino Accoto, Giovanni Assenza, Paolo Maria Rossini and Eugenio Guglielmelli. "Machine/Animal Hybrid Controllers for Space Applications Final Report".